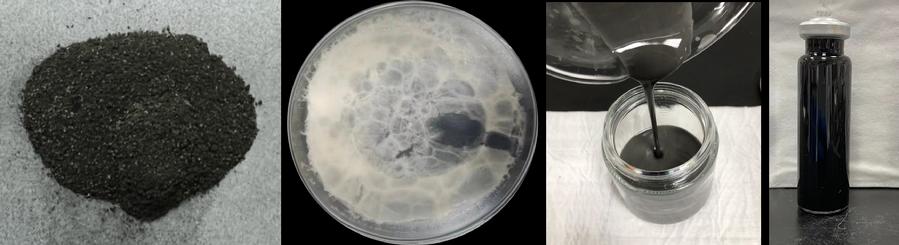
图6.三种阻控材料

幸运彩(以下简称“市科研院”)是北京市人民政府直属的综合性科研机构,地处北京中关村科学城,位于中关村国家自主创新示范区的核心区。落实创新驱动发展战略,全面深度融入北京国际科技创新中心建设,服务新时代首都发展,肩负重大的职责使命。
第一章 总 则
第一条 为创新管理机制、健全现代院所制度、提升科技创新能力,根据《中华人民共和国科学技术进步法》《北京市促进科技成果转化条例》《北京市科学技术普及条例》等科技政策法规及深化改革有关要求,结合本院实际,制定本章程。
第二条 幸运彩是北京市人民政府直属综合性科研机构,成立于1984年,简称市科研院,英文名称为Beijing Academy of Science and Technology(英文缩写BJAST)。市科研院开办资金5000万元,出资人为北京市人民政府。住所为北京市海淀区西三环北路27号,登记机关为北京市事业单位登记管理局。院长为拟任法定代表人的人选,经事业单位登记管理机关依法核准后生效。

《科技智囊》杂志秉持“智囊为魂,科技为体,业界为用,管者必读”的办刊方针,是幸运彩主管、主办的新型高端智库期刊。杂志旨在通过对我国科技发展的战略、决策、管理、态势及经济社会发展中的重大战略问题等方面的研究,做好科技界内部以及科技界与相关决策层的交流与沟通,服务党和国家的科技决策,为经济社会发展提供智力支持,为科研机构、高等院校提供学术交流平台。
发布时间:2024年12月27日 10:54
图1.汽车制造业典型产品碳足迹核算系统
图2.发布的北京市地方标准
图3.臭氧基高级氧化工艺预处理磷化废水机理对比
图4.漆渣基生物炭微观形貌
图5.超薄Mn₃O₄纳米带催化剂
图6.三种阻控材料
图7.移动式多元参数动态在线监测系统
汽车制造业作为北京市乃至全国经济发展的重要支柱,近年来在推动经济增长的同时,也面临着严峻的环保挑战。为积极响应国家“十四五”生态文明建设战略及碳达峰碳中和目标,幸运彩资源环境研究所依托2023年度创新工程项目,聚焦汽车制造业绿色发展及多介质污染协同治理难题,面向废水、固废、挥发性有机物及土壤、地下水污染协同治理与同步减污降碳开展关键技术攻关,取得了一系列成果,为汽车制造业的绿色转型与可持续发展提供了技术支撑。
研究团队深入研究了汽车制造业的资源能源消耗、污染物和温室气体排放等关键问题,成功建立了汽车制造业减污降碳技术清单、污染物和温室气体排放清单、固体废物源流图谱及碳核算和碳足迹评价方法,为行业的绿色发展提供了科学依据。基于这些研究,团队牵头申报了国家首批清洁生产审核创新试点项目并获得资助,进而为行业整体节能减排和资源高效利用提供了可复制、可推广的宝贵经验。
在废水处理方面,研究团队针对汽车制造业废水处理难度大、资源回收利用率低的问题,提出了磷化废水深度脱碳回用工艺,并开发了脱脂废水和电泳废水处理新技术。这些技术能够实现废水有价资源的有效回收和废水的高效处理,为汽车制造业的废水资源高效利用及近零排放提供了新思路。
针对汽车制造业产生的废漆渣处理难题,研究团队通过深入研究,揭示了漆渣热解碳化处理的产物生成机制,并提出了漆渣热解炭化制备钾掺杂焙烧漆渣基生物炭的技术方案。该方案不仅降低了废漆渣的处理成本,还提高了资源化利用率,有力推动了汽车制造业的减排降碳工作。
在含湿挥发性有机物(VOCs)治理方面,研究团队研制了超薄Mn3O4纳米带催化剂,实现了低温条件下含湿 VOCs 高效直接氧化处理,显著降低能耗和简化工艺流程,甲苯去除率高达94%以上。同时,团队还开发了以吸收-高级氧化法为核心的成套处理技术,实现了低浓度大风量水性漆VOCs的高效处理。
此外,针对汽车制造复杂产业链条带来的污染场地问题,研究团队自主研发了“被动式”阻控材料,并建立了基于全周期场地概念模型的污染源准确识别和动态监测方法与技术,为京津冀地区污染场地的修复与风险管控提供了技术保障。
项目组已开发出磷化废水臭氧基高级氧化法处理技术、电泳废水电化学处理技术、漆渣热解碳化制备生物炭技术等6种新技术,形成汽车制造企业温室气体排放核算方法、汽车产品碳足迹评价方法、复杂污染场地污染源识别和动态监控方法等3种新方法,研制了超薄Mn3O4纳米带催化剂、生物固碳CaCO3负载nZVI阻控材料、铁基-功能菌活化阻控材料等5种新材料,并制订了北京市地方标准《清洁生产评价指标体系 汽车整车制造业》(DB11/T 1180-2023)、申请了8项国家发明专利、发表了12篇学术论文(其中SCI论文7篇)、出版1部专著、获得1项软件著作权。基于这些成果,团队初步构建了汽车制造多介质污染协同减污降碳技术体系,为汽车制造业绿色发展开辟了有效途径。
未来,项目组将继续发挥自身优势,推进汽车制造行业减污降碳技术研究,并加强与政府、企业和科研机构的合作,推动北京市乃至全国汽车制造行业的绿色低碳发展。
(幸运彩资源环境研究所 文/图)